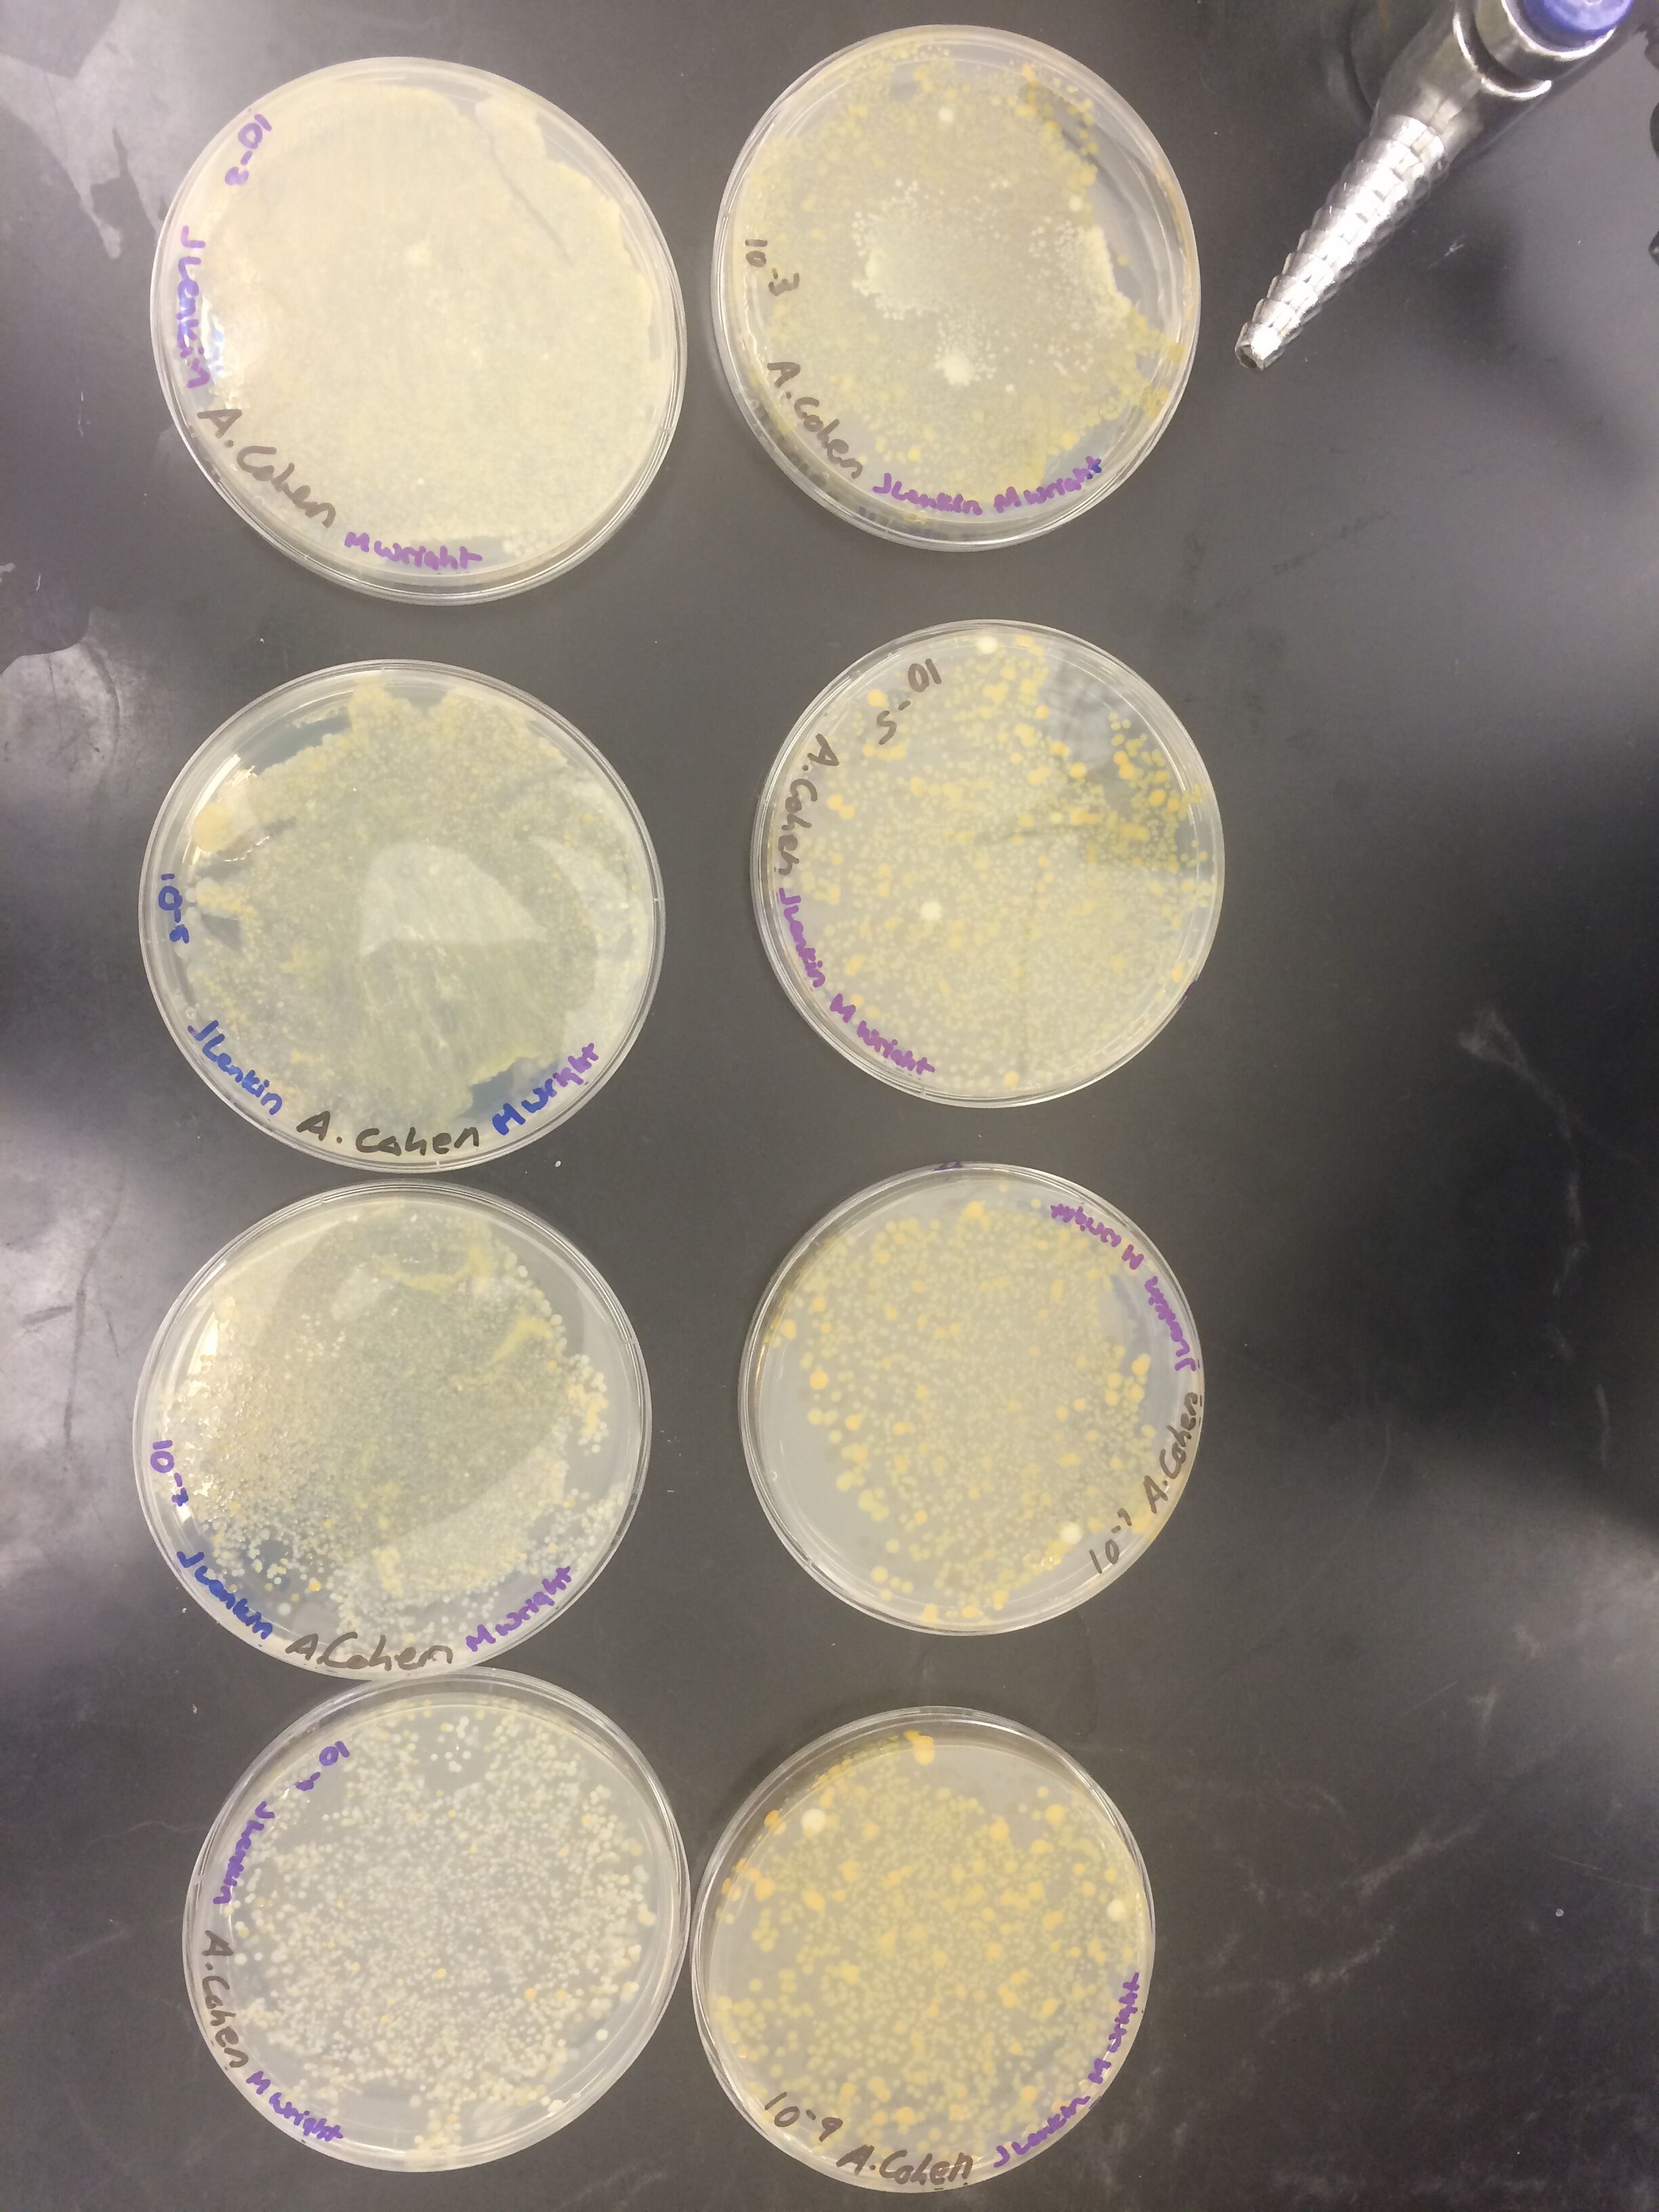

User:Morgan M. Wright/Notebook/Biology 210 at AU
BIO 210 Lab #5 Invertebrates and Vertebrates 07/14/15 & 07/12/15 Introduction This lab had us examining invertebrate and vertebrate specie in our transect. Although very diverse, the majority of the invertebrates found were arthropods. Vertebrates were also observed.
Methods We collected our invertebrates through a Berlese funnel. We then observed the invertebrates with the naked eye and used a dichotomous key to classify. We observed the vertebrates in our transect by hand.
Results

 tables created by group member Austin Cohen
tables created by group member Austin Cohen
Discussion Although there was not a lot of diversity in our transect, there community had a lot of life. The foodweb above illustrates the inter-connectivity of our transect.
BIO 210- Lab #4 Plant Life in the Transect 07/09/15
INTRODUCTION In this lab we revisited our transect. We observed the plant life. Plant are extremely important to all ecosystems as they produce O2 and Glucose. There are many species of plants in all sorts of shapes and sizes. Plants have adapted to land with a variety of adaptations including seeds. Plant seeds are either Monocotic or Dicotic. The Mono or Di refers to the number of reproductive structures within the seeds. Dicots are more complex thus a more recent plant trait than monocots.
METHODS We first gathered leaf litter from all over our transect. We used this material in a Berlese funnel to collect invertebrates. To set the Berlese funnel up we took a funnel, put a filtering mesh inside in the bottom of the funnel and a test tube containing 50/50 ethanol/water on the bottom. We then put the leaf litter inside the funnel and set up the funnel so that a 40 watt lamp was directly above the funnel. The funnel-lamp apparatus was wrapped in tin foil and left to sit. Additionally, at our transect, we documented 5 distinct plants with photographs as well as taking physical samples for identification purposes. We used a variety of online resources to help identify the plants.
RESULTS
| Sample Plants | Location of Plants | Size and Shape | Vascularization | Specialization | Mechanism of Reproduction
|
| Broad Leaf Plantain | 1 | Waxy, Broad leafs | Dicot | flowers and stomata | Flowers and pollen |
| White Clover | 2 | Three leaf structure with white flowers | Dicot | flowers and stomata | Flowers and pollen |
| Japanese Pagoda Tree | 3 | 10 to 15 feet high with narrow trunk | Dicot | flowers, stomata, and trunk | Flowers and pollen |
| False Dandelion | 4 | narrow serated leafs | Dicot | flowers and stomata | Flowers and pollen |
| Crab Grass | 5 | Short Narrow leafs under 15cm | Monocot | flowers and stomata | Flowers and pollen |
Locations (Map by group member Austin Cohen)

DISCUSSION This lab gave us insight to the diversity of plant life sitting right under our noses. We were able to find both examples of mono and dicot plants living in the same transect. Even among the many examples of dicot plants we collected there was an extreme amount of differences in form and structure. The Berlese funnel will give us a new biotic component of our transect to analyze. In the ziplock bag prior to the funnel I noticed ants crawling around.
BIO 210- Lab #3 Microbiology and Identifying Bacteria with DNA Sequence 07/07/15
INTRODUCTION In lab 3, we revisited the bacteria we grew on agar plates and observed the colonies they formed. We identified bacteria taken from the colonies and we set up a a PCR test to amplify a specific gene (16s) in the bacteria. There were 8 plates total which we grew bacteria on. The plates were of different dilutions. Half (4) of the plates were treated with the anti-biotic, Tetracycline. Tetracycline's mechanism of action is inhibiting bacterial protein synthesis (Chopra & Roberts 2001). Because tetracycline only acts on bacteria, non-bacterial microorganisms can flourish and fill the void left by the tetracycline affected bacteria.
METHODS After a week (7 days) the bacterial plates were observed. Size, shape, color, and other details were observed. We chose 4 colonies from two plates to observe under a microscope. We made a wet mount of these samples. We used a sterile loop to transfer the colonies to a slide. The bacteria was then fixed via Bunsen burner. After fixation, we did a Gram Stain on the slides. After the staining process, the 4 slides were viewed under a microscope. We observed various characteristics of the bacteria on the slides we prepared. Lastly, we prepared a PCR solution with two colonies from one tetracycline plate and one plate without tetracycline. We placed one of the small colonies of bacteria into 25 uL of master mix with .5 uM of primer solution. We did the same for the other colony. The PCR mix was then immersed in a hot water bath pending the PCR process.
RESULTS We checked our Hayes infusion once more. The sediment had settled on the bottom and the biofilm on the surface had grown significantly leaving he middle section of the solution relatively clear. The surface biofilm was the same color as lats time- dark brown. We sniffed the Hayes solution and it smelled like manure like before. However, there was a more metallic smell to it. Two of our colonies were Gram positive and two of our colonies were gram negative. Serial Dilution Results:
| Dilution | Agar Type | No. of Colonies | Conversion Factor | Colonies per mL |
| 10^-3 | Nutrient | Lawn | X10^3 | N/A |
| 10^-5 | Nutrient | Lawn | X10^5 | N/A |
| 10^-7 | Nutrient | Lawn | X10^7 | N/A |
| 10^-9 | Nutrient | Thousands | X10^9 | N/A |
| 10^-3 | Nutrient and Tetracyline | Lawn | X10^3 | N/A |
| 10^-5 | Nutrient and Tetracyline | Hundreds | X10^5 | N/A |
| 10^-7 | Nutrient and Tetracyline | Hundreds | X10^7 | N/A |
| 10^-9 | Nutrient and Tetracyline | Hundreds | X10^9 | N/A |
Bacterial Characterization: All of the bacteria colonies we observed were circular in shape and slightly raised. There were only yellow and white colonies on our plates with far more yellow than white colonies. None of the colonies we observed were motile. Both bacteria from the colonies we observed were a cocci shape. The colonies their selves ranged in diameter from .05 to 3mm.
Picture of bacterial extraction

DISCUSSION There was not as big of a distinction in the growth of the bacteria between the tetracycline positive and negative plates as I expected although the average colony size of the tetracycline positive plates was smaller than the negative plates. Additionally, there were fewer lawns in the tetracycline positive plates. We also observed Gram staining in action and used the process to help observe bacteria from the colonies we grew.
Chopra, I., & Roberts, M. (2001). Tetracycline Antibiotics: Mode of Action,
Applications, Molecular Biology, and Epidemiology of Bacterial Resistance.
Microbiology and Molecular Biology Reviews, 65(2), 232–260.
doi:10.1128/MMBR.65.2.232-260.2001
BIO 210- Lab #2 Identifying Algae and Protists 7/2/15
INTRODUCTION Most protists and algae are too small to see with the naked eye. We use a microscope to allow us to view these micro-organisms. A dichotomous key is used to determine which organism is being observed. It works by running a series of questions which exclude certain known organisms. The questions ask about color, size, and the forms of motility.
METHODS The Hayes infusion jar was retrieved. It had separated into a biofilm on top and sediment on bottom. Two samples were taken from two niche areas of the jar. We chose to take two samples from directly above the sediment on the bottom of the jar and two samples from just under the biofilm the surface of the jar. We used these samples to create a wet mount and observed organisms under a microscope. We used a Dichotomous key to assist in identification of the organisms. We also created a serial dilution derived from our Hayes infusion. There were 8 plates containing nutrient solution, 4 of which contained an anti-biotic. The dilutions were 10^-2, 10^-4, 10^-6, and 10^-8.
RESULTS
We identified 4 organisms. Gonium (90um) and Peranema(60um) were identified in the samples taken near the surface. Stentor (1mm), Colpdium(50um), and Spirostromium (1mm) were identified from the sample taken near the bottom. The jar appeared to have some mold on the surface. The jar smelled like manure and was very offensive to the nose. There was no evidence of plant life such as green shoots. Organisms who live near the biological matter in our Hayes infusion are either eating the biological matter or consuming those who are eating the biological matter. All of the organisms we observed are non-photosythetic. If the Hay infusion culture grew another two months, I would expect to see more and more of fewer and fewer species as certain organisms out compete each other for the limited amount of resources in the jar.
Peranema is alive because it is comprised of cell(s), it uses energy, it reproduces (passes down information), and it evolves and in doing so fills a niche in the micro-ecosystem that is the Hayes infusion.
Picture of Serial Dilution diagram.

DISCUSSION We found many more organisms than the 5 we identified including some the Dichotomous key was unable to assist in identification. Through viewing organisms from our Hayes infusion under a microscope, we gained an better understanding of the biotic factors of our transect and of American University's environment. Upon viewing our serial dilution we will be able to better observe what biotic organisms had been living in the soil in my transect.
mw
BIO 210- LAB #1 The Transect and Volvocine Line 6/30/15
INTRODUCTION Simply put, a transect is a slice of land. We chose a transect on American University's campus and observed both the biotic and abiotic features of the ecosystem to which our transect belongs. From our transect we can extrapolate about the abiotic and biotic features of other transects on American University's campus. My transect was marshy but there was no standing water.
METHODS A 20 foot by 20 foot transect was charted out by hand between McCabe, Clark, and Gray hall. Various biotic and abiotic factors of the transect were observed. Pictures were taken to document the transect. A soil sample was also taken for a Hayes infusion in which 10 grams of soil was mixed with 500ml of water and .1g of dried milk in a jar. The jar was then shaken and left to sit with its lid off for a period of 2 nights.
RESULTS
The transect was in the sun most of the day with no shade until the sun almost sets. There was a slight slant to the land with the southern side of the transect slightly sloping to the northern side. The isolation of the transect led to very little foot traffic relative to other grassy areas of American University's campus. The soil was very moist. There were breaks in the vegetation coverage on the ground revealing small rocks mixed in with the clay-like soil. There was also moss between the patches of grass. The dominant plant appeared to be clover which covered up the majority of the ground in the transect however, grass and weeds also were present. Some additional biotic factors we observed were several squirrels running around our transect and the tress closest to our transect as well as birds who flew in and out of our transects space. Abiotically, the sun, wind, and air/ground temperature undoubtedly influence what my transect looks like in different seasons. Furthermore, the high clay content in the soil is an abiotic factor which influences the high moisture content of the soil.
The file below was taken on the 90 degree northernmost corner of my transect and is looking south east across the transect to the other 90 degree corner of the transect.
 The files below illustrate the vegetation found in my transect.
The files below illustrate the vegetation found in my transect.

 IMG_4996.jpg
DISCUSSION:
Observing my transect provides an insight into the ecosystem at American University. There were many biotic and abiotic features of my transect. In preparing a Hayes infusion, I will be able to observe more of the biotic features under microscope.
IMG_4996.jpg
DISCUSSION:
Observing my transect provides an insight into the ecosystem at American University. There were many biotic and abiotic features of my transect. In preparing a Hayes infusion, I will be able to observe more of the biotic features under microscope.
mw